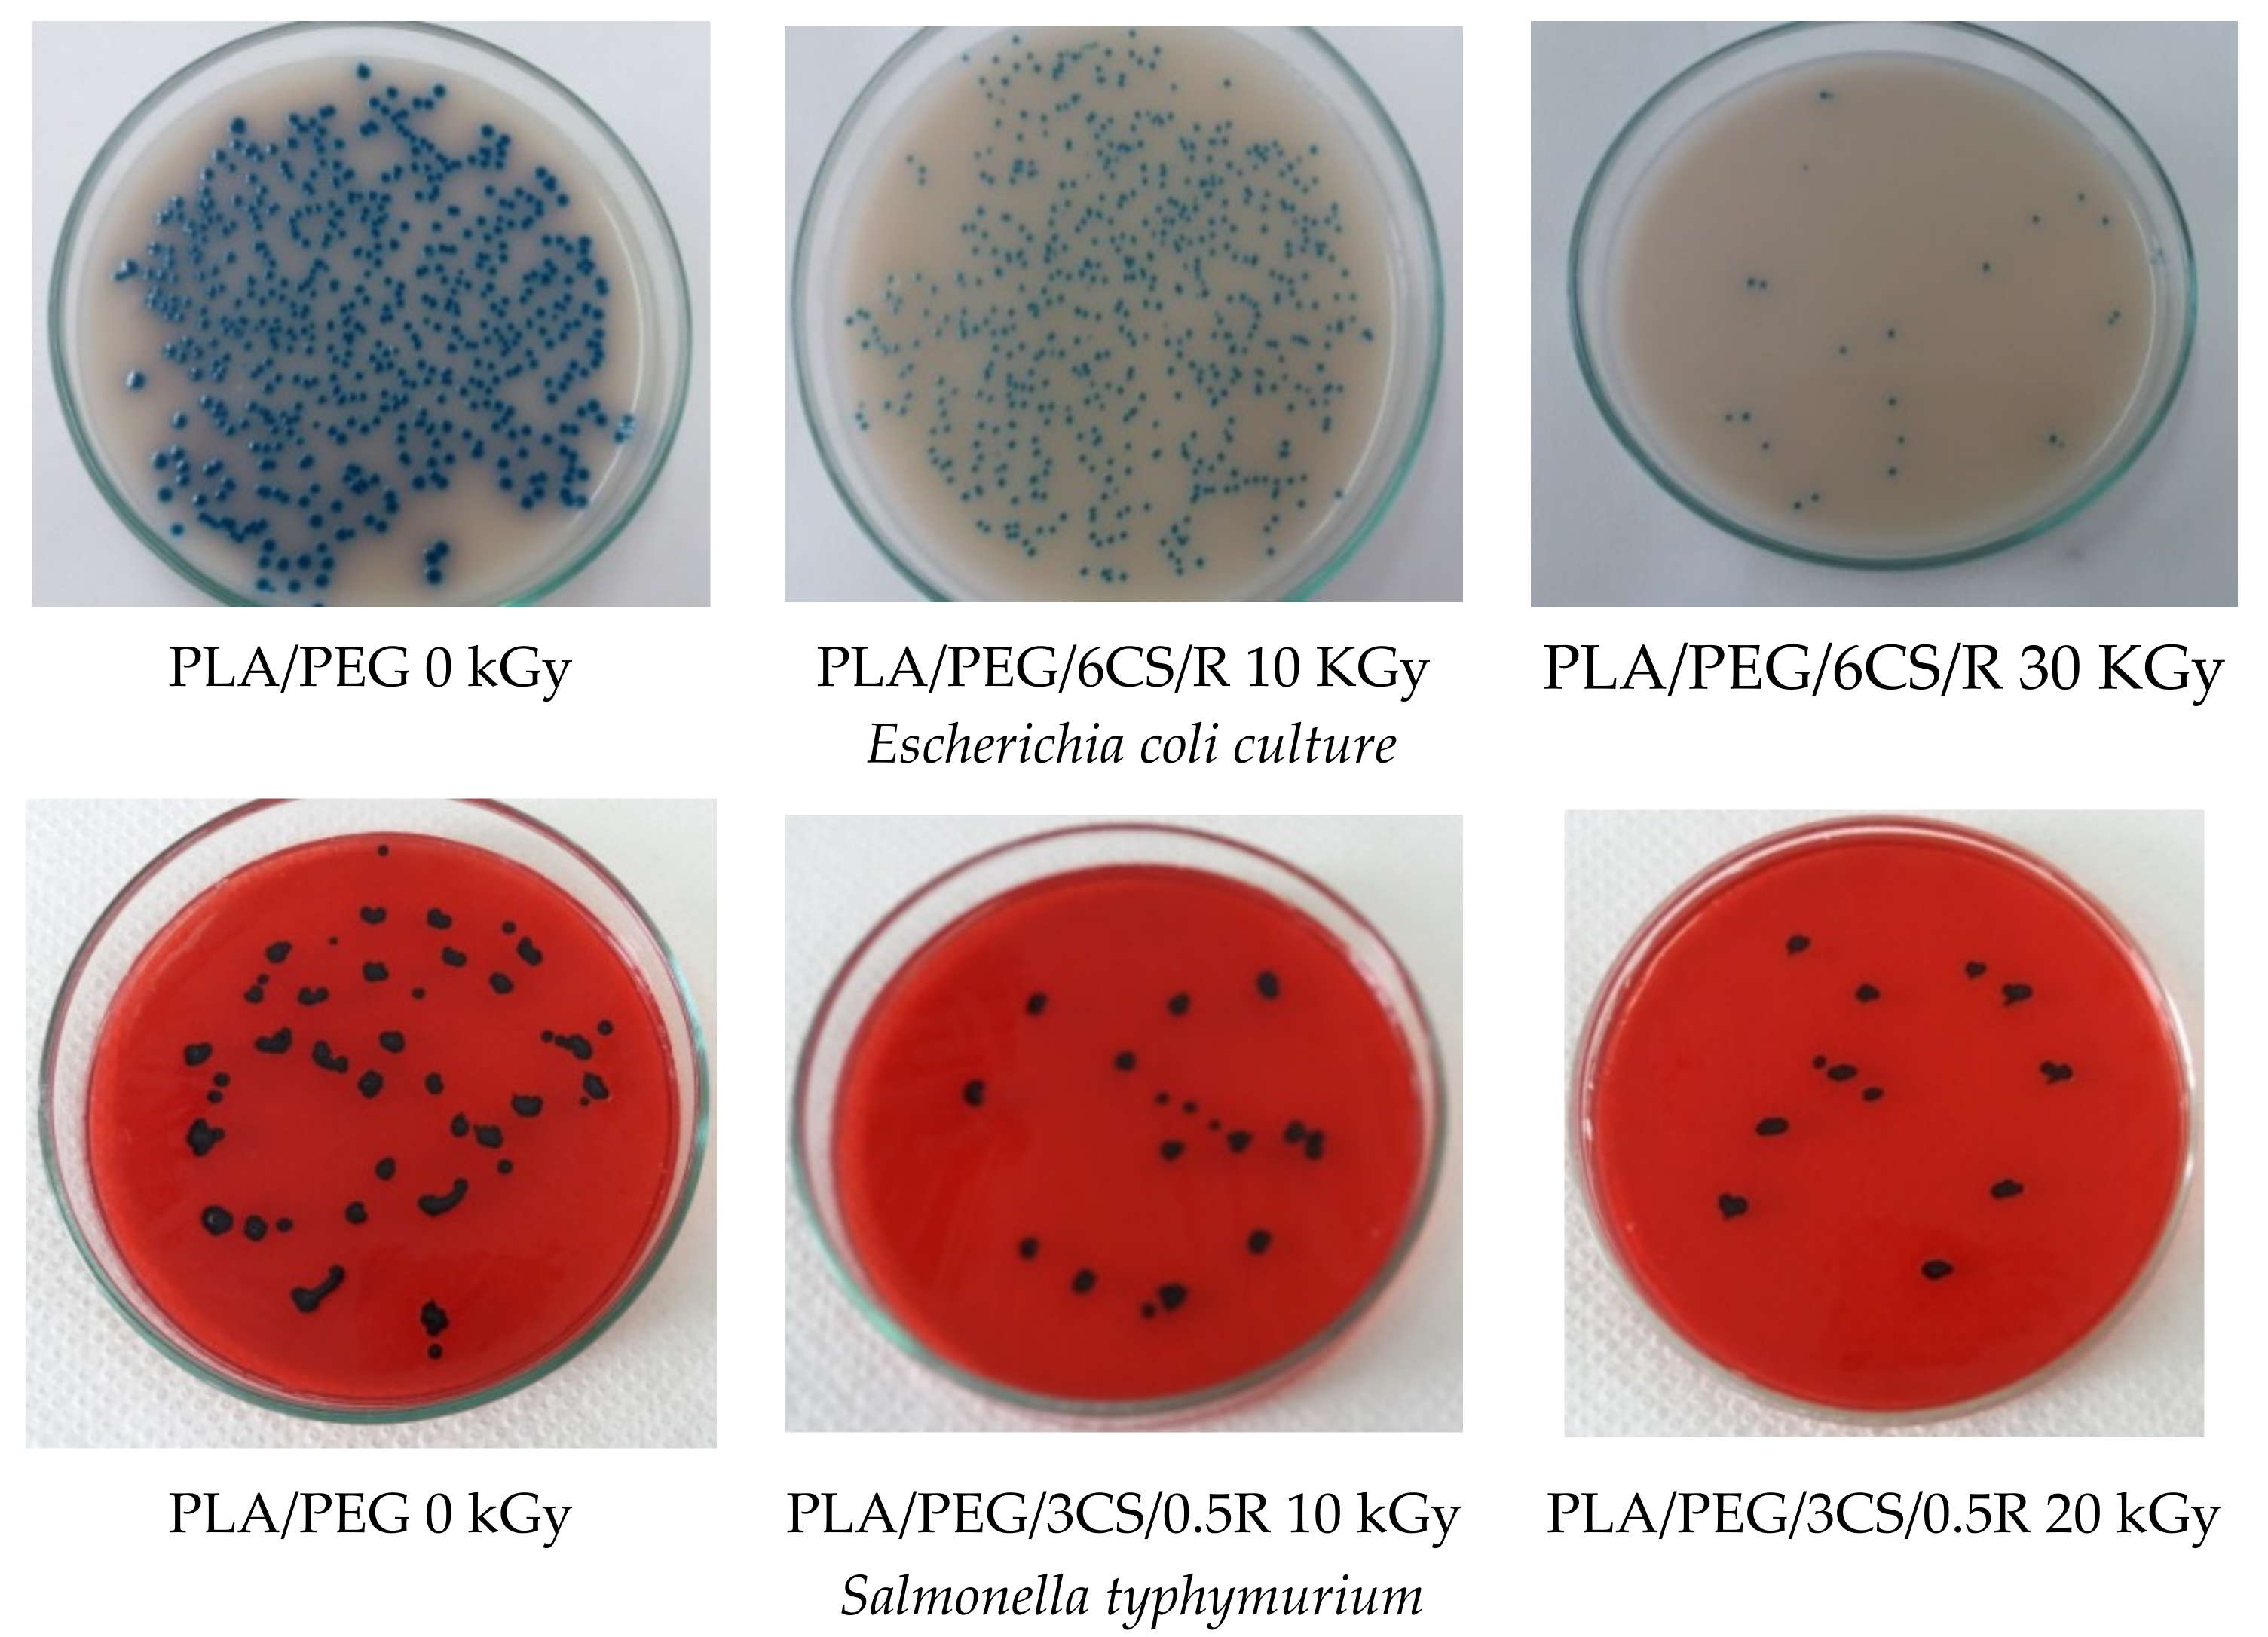
Polymers 14 01398 g014a 550
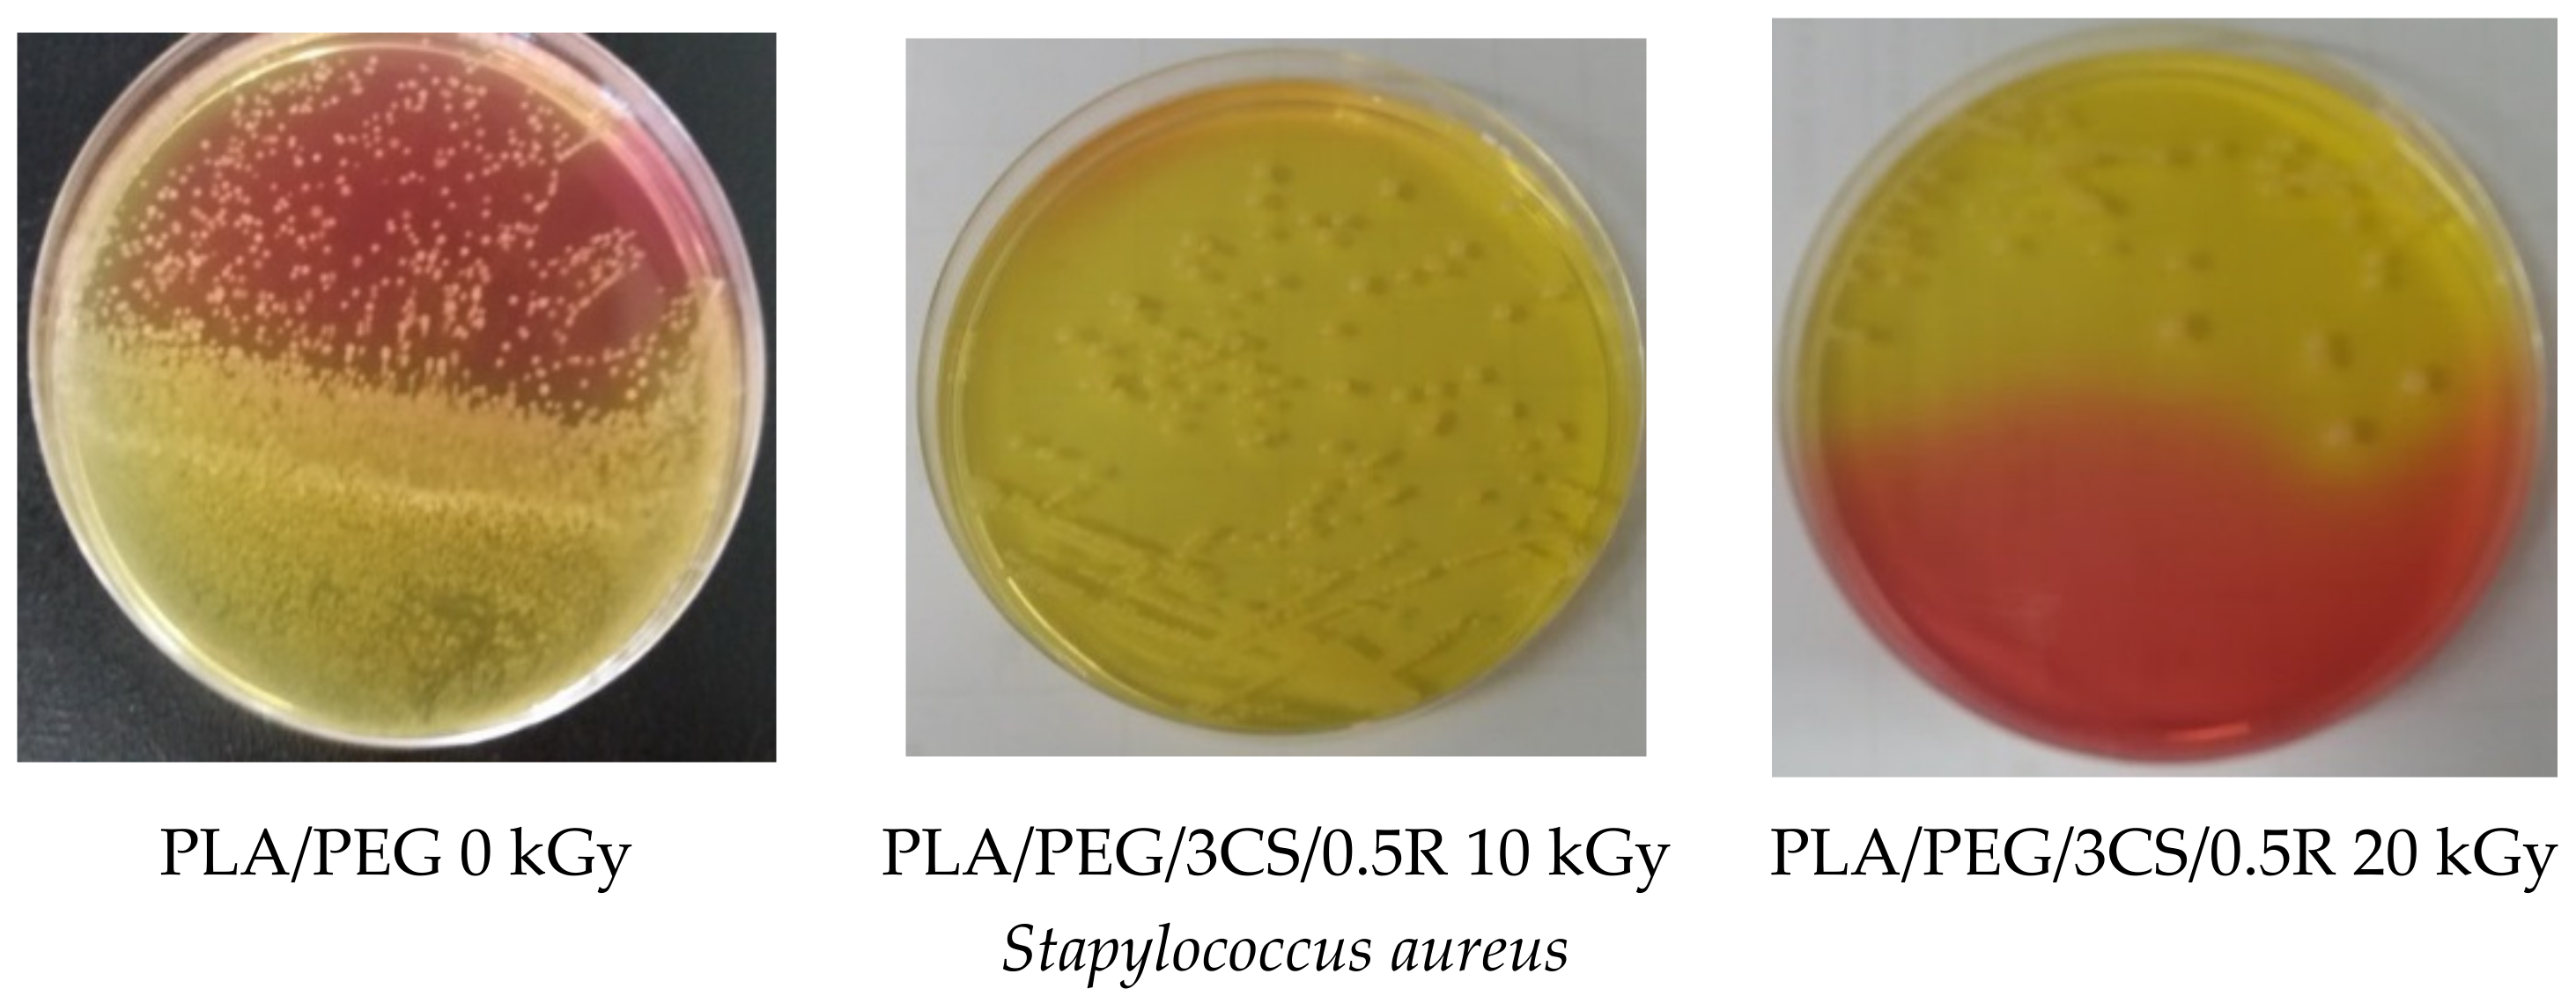
Polymers 14 01398 g014b 550

Effect of Gamma Irradiation on the PLA-Based Blends and Biocomposites Containing Rosemary Ethanolic Extract and Chitosan
Abstract
:1. Introduction
2. Materials and Methods
2.1. Materials
2.2. Biocomposite Preparation
2.3. Radiochemical Processing
2.4. Investigation Methods
2.4.1. Scanning Electron Microscopy (SEM)
2.4.2. ATR–FTIR Spectroscopy
2.4.3. Differential Scanning Calorimetry (DSC)
2.4.4. Thermogravimetry (TG)
2.4.5. Chemiluminescence (CL)
2.4.6. Bioactive Compounds Release and Migration Kinetics Investigation
2.4.7. Antibacterial Activity
- Sterilization of the samples, performed in an autoclave at 110 °C, 0.5 bars for 20 min.
- Preparation of ATCC cultures by: seeding an average pre-enrichment and incubation at 37 °C for 24 h; counting the colonies in 0.1 mL culture by selective culture medium separation. Seeding of 0.1 mL bacterial culture ATCC using sterile swab sample surfaces. Both samples and reference (blank as plastic food foil) were inoculated with 10 µL inoculum ATCC containing 105 UFC/mL.
- Incubation of samples contaminated with the ATCC for 24 h at 25 °C, in the dark, in sterilized glass containers, was repeated after 24 h of incubation; using a sterile swab, the inoculated surface was cleaned with physiological saline. Then, the surfaces were seeded with the selective media such as XLD for Salmonella, Rambach for E. coli, and Chapmann for Staphlococcus aureus.
- Identifying target germs was undertaken following standardized methods of bacteriology procedures, according to standards in force: SR ISO 16649 for E. coli; SR EN ISO 6579 for Salmonella sp.; and SR EN ISO 6888 for Staphylococcus aureus.
3. Results and Discussion
3.1. Scanning Electron Microscopy (SEM)
3.2. FTIR Spectroscopy
3.3. Thermal Properties
3.3.1. Differential Scanning Calorimetry (DSC) Results
3.3.2. Thermogravimetry (TG) Results
3.4. Chemiluminescence (CL)
3.5. Bioactive Compounds Release Study and Migration Kinetics of the Rosemary Extract Components from Irradiated and Non-Irradiated PLA/PEG/CS-Based Films
3.6. Antibacterial Activity
4. Conclusions
Author Contributions
Funding
Institutional Review Board Statement
Informed Consent Statement
Data Availability Statement
Conflicts of Interest
References
- Byun, M.-W.; Lee, J.-W.; Yook, H.-S.; Jo, C.; Kim, H.-Y. Application of gamma irradiation for inhibition of food allergy. Radiat. Phys. Chem. 2002, 63, 369–370. [Google Scholar] [CrossRef]
- Piri, I.; Babayan, M.; Tavassoli, A.; Javaheri, M. The use of gamma irradiation in agriculture. Afr. J. Microbiol. Res. 2011, 5, 5806–5811. [Google Scholar]
- Haji-Saeid, M.; Sampa, M.H.O.; Chmielewski, A.G. Radiation treatment for sterilization of packaging materials. Radiat. Phys. Chem. 2007, 76, 1535–1541. [Google Scholar] [CrossRef]
- Almasi, H.; Oskouie, J.M.; Saleh, A. A review on techniques utilized for design of controlled release food active packaging. Crit. Rev. Food Sci. Nutr. 2021, 61, 2601–2621. [Google Scholar] [CrossRef] [PubMed]
- EC. Directive 1999/2/EC of the European Parliament and of the Council of 22 February 1999 on the approximation of the laws of the Member States concerning foods and food ingredients treated with ionising radiation (OJ L 66, 13.3.1999, pp. 16–23)The establishment of a community fruit list of food and food ingredients treated with ionizing radiation. Off. J. Eur. Communities 1999, 66, 24–25. [Google Scholar]
- Food Irradiation. Available online: https://en.wikipedia.org/wiki/Food_irradiation (accessed on 15 December 2021).
- Morehouse, K.M.; Komolprasert, V. Irradiation of Food and Packaging: An Overview. ACS Symp. Ser. 2004, 875, 1–11. [Google Scholar] [CrossRef] [Green Version]
- Al-Masry, W.A.; Haider, S.; Mahmood, A.; Khan, M.; Adil, S.F.; Siddiqui, M.R.H. Evaluation of the Thermal and Morphological Properties of γ-Irradiated Chitosan-Glycerol-Based Polymeric Films. Processes 2021, 9, 1783. [Google Scholar] [CrossRef]
- Sabaghi, M.; Maghsoudlou, Y.; Kashiri, M.; Shakeri, A. Evaluation of release mechanism of catechin from chitosan-polyvinyl alcohol film by exposure to gamma irradiation. Carbohydr. Polym. 2020, 230, 115589. [Google Scholar] [CrossRef]
- Vasile, C. Radiation Mediated Bioactive Compounds Immobilization on Polymers to Obtain Multifunctional Food Packaging Materials. In Proceedings of the International Conference on Applications of Radiation Science and Technology (ICARST-2017), Vienna, Austria, 24–28 April 2017; Available online: https://media.superevent.com/documents/20170425/8584c618df6eb47383529f034c356728/c.-vasile.pdf (accessed on 5 January 2022).
- Kodal, M.; Wis, A.A.; Ozkoc, G. The mechanical, thermal and morphological properties of γ-irradiated PLA/TAIC and PLA/OvPOSS. Radiat. Phys. Chem. 2018, 153, 214–225. [Google Scholar] [CrossRef]
- Salgado, P.R.; Di Giorgio, L.; Musso, Y.S.; Mauri, A.N. Recent Developments in Smart Food Packaging Focused on Biobased and Biodegradable Polymers. Front. Sustain. Food Syst. 2021, 5, 125. [Google Scholar] [CrossRef]
- Martínez-Barrera, G.; Ávila-Córdoba, L.I.; Martínez-López, M.; Herrera-Sosa, E.S.; Vigueras-Santiago, E.; Barrera-Díaz, C.E.; Ureña-Nuñez, F.; González-Rivas, N. Chapter 11: Gamma Radiation as a Recycling Tool for Waste Materials Used in Concrete. In Evolution of Ionazing Radiation Research; Nenoi, M., Ed.; InTechEditors: London, UK, 2015. [Google Scholar] [CrossRef] [Green Version]
- Filiciotto, L.; Rothenberg, G. Biodegradable Plastics: Standards, Policies, and Impacts. ChemSusChem 2021, 14, 56–72. [Google Scholar] [CrossRef] [PubMed]
- Saito, O. On the Effect of High Energy Radiation to Polymers. I. Cross-linking and Degradation. J. Phys. Soc. Jpn. 1958, 13, 198–206. [Google Scholar] [CrossRef]
- Bednarek, M.; Borska, K.; Kubisa, P. Crosslinking of Polylactide by High Energy Irradiation and Photo-Curing. Molecules 2020, 25, 4919. [Google Scholar] [CrossRef] [PubMed]
- West, C.; McTaggart, R.; Letcher, T.; Raynie, D.; Roy, R. Effects of Gamma Irradiation Upon the Mechanical and Chemical Properties of 3D-Printed Samples of Polylactic Acid. J. Manuf. Sci. Eng. 2019, 141, 041002. [Google Scholar] [CrossRef]
- Refaee, A.M.E.A. Radiation Effects on Some Polymeric Materials and Their Utilization for Possible Practical Applications. Master’s Thesis, Faculty of Science, Chemistry Department, Ain Shams University, Cairo, Egypt, 2008. Available online: https://www.osti.gov/etdeweb/servlets/purl/21144281 (accessed on 20 November 2021).
- Matsuhashi, S.; Kume, T. Enhancement of Antimicrobial Activity of Chitosan by Irradiation. J. Sci. Food Agric. 1997, 73, 237–241. [Google Scholar] [CrossRef]
- Yoksan, R.; Akashi, M.; Miyata, M.; Chirachanchai, S. Optimal γ-ray Dose and Irradiation Conditions for Producing Low-Molecular-Weight Chitosan That Retains Its Chemical Structure. Radiat. Res. 2004, 161, 471–480. [Google Scholar] [CrossRef]
- García, M.A.; Pérez, L.; de la Paz, N.; González, J.; Rapado, M.; Casariego, A. Effect of molecular weight reduction by gamma irradiation on chitosan film properties. Mater. Sci. Eng. C 2015, 55, 174–180. [Google Scholar] [CrossRef]
- Munteanu, S.B.; Vasile, C. Vegetable Additives in Food Packaging Polymeric Materials. Polymers 2020, 12, 28. [Google Scholar] [CrossRef] [Green Version]
- Munteanu, S.B.; Vasile, C. Encapsulation of Natural Bioactive Compounds by Electrospinning—Applications in Food Storage and Safety. Polymers 2021, 13, 3771. [Google Scholar] [CrossRef]
- Darie-Nita, R.N.; Rapa, M.; Sivertsvik, M.; Rosnes, J.T.; Popa, E.E.; Dumitriu, R.P.; Marincas, O.; Matei, E.; Predescu, C.; Vasile, C. PLA-Based Materials Containing Bio-Plasticizers and Chitosan Modified with Rosehip Seed Oil for Ecological Packaging. Polymers 2021, 13, 1610. [Google Scholar] [CrossRef]
- Vasile, C.; Stoleru, E.; Darie-Nita, R.N.; Dumitriu, R.P.; Pamfil, D.; Tartau, L. New Biocompatible Materials Based on Plasticized Poly(lactic acid), Chitosan and Rosemary Ethanolic Extract, I. Effect of Chitosan on the Properties of Plasticized Poly(lactic acid) Materials. Polymers 2019, 11, 941. [Google Scholar] [CrossRef] [PubMed] [Green Version]
- Darie-Niţă, R.N.; Vasile, C.; Stoleru, E.; Pamfil, D.; Zaharescu, T.; Tarţău, L.; Tudorachi, N.; Brebu, M.A.; Pricope, G.M.; Dumitriu, R.P.; et al. Evaluation of the Rosemary Extract Effect on the Properties of Polylactic Acid-Based Materials. Materials 2018, 11, 1825. [Google Scholar] [CrossRef] [PubMed] [Green Version]
- Vasile, C.; Tudorachi, N.; Zaharescu, T.; Darie-Nita, R.N.; Cheaburu-Yilmaz, C.N. Study on Thermal Behavior of Some Biocompatible and Biodegradable Materials Based on Plasticized PLA, Chitosan, and Rosemary Ethanolic Extract. Int. J. Polym. Sci. 2020, 4269792. [Google Scholar] [CrossRef]
- Stoleru, E.; Hitruc, E.G.; Vasile, C.; Oprica, L. Biodegradation of poly(lactic acid)/chitosan stratified composites in presence of the Phanerochaete chrysosporium fungus. Polym. Degrad. Stab. 2017, 143, 118–129. [Google Scholar] [CrossRef]
- Stoleru, E.; Vasile, C.; Oprică, L.; Yilmaz, O. Influence of the Chitosan and Rosemary Extract on Fungal Biodegradation of Some Plasticized PLA-Based Materials. Polymers 2020, 12, 469. [Google Scholar] [CrossRef] [Green Version]
- Available online: https://www.twi-global.com/technical-knowledge/faqs/what-is-pla (accessed on 29 October 2021).
- Zaharescu, T.; Jipa, S.; Kappel, W.; Artenie-Mariş, D.; Mariş, M.; Mantsch, A. Effect of rosemary extract on the radiation stability of UHMWPE. E-Polymers 2009, 1, 149. [Google Scholar] [CrossRef] [Green Version]
- Troncoso, N.; Sierra, H.; Carvajal, L.; Delpiano, P.; Gunther, G. Fast high performance liquid chromatography and ultraviolet–visible quantification of principal phenolic antioxidants in fresh rosemary. Proceedings 2005. Available online: https://pdfs.semanticscholar.org/d0cc/20a8c2a3018b485779ca1803408df7ecc7a3.pdf (accessed on 15 February 2022). [CrossRef]
- Budrugeac, P.; Segal, E. Applicability of the Kissinger equation in thermal analysis: Revisited. J. Therm. Anal. Calorim. 2007, 88, 703–707. [Google Scholar] [CrossRef]
- Wellen, R.M.R.; Canedo, E.L. On the Kissinger equation and the estimate of activation energies for non-isothermal cold crystallization of PET. Polym. Test. 2014, 40, 33–38. [Google Scholar] [CrossRef] [Green Version]
- EC. Commission Regulation (EU) No 10/2011 of 14 January 2011 on Plastic Materials and Articles Intended to Come into Contact with Food. Commission Directive 2002/72/EC. Off. J. Eur. Union 2011, 12, 1–89. [Google Scholar]
- EU. JRC Science and Policy Reports, Technical Guidelines for Compliance Testing. In The Framework of Regulation (EU) No. 10/2011 on Plastic Food Contact Materials/Draft for Consultation; European Commission: Luxembourg, 2011. [Google Scholar]
- Mulinacci, N.; Innocenti, M.; Bellumori, M.; Giaccherini, C.; Martini, V.; Michelozzi, M. Storage method, drying processes and extraction procedures strongly affect the phenolic fraction of rosemary leaves: An HPLC/DAD/MS study. Talanta 2011, 85, 167–176. [Google Scholar] [CrossRef] [PubMed]
- Zhang, Y.; Smuts, J.P.; Dodbiba, E.; Rangarajan, R.; Lang, J.C.; Armstrong, D.W. Degradation study of carnosic acid, carnosol, rosmarinic acid, and rosemary extract (Rosmarinus officinalis L.) assessed using HPLC. J. Agric. Food Chem. 2012, 60, 9305–9314. [Google Scholar] [CrossRef] [PubMed]
- Poças, M.F.; Oliveira, J.C.; Oliveira, F.A.R.; Hogg, T. A critical survey of predictive mathematical models for migration from packaging. Crit. Rev. Food Sci. Nutr. 2008, 48, 913–928. [Google Scholar] [CrossRef] [PubMed]
- Hachana, N.; Wongwanchai, T.; Chaochanchaikul, K.; Harnnarongchai, W. Influence of Crosslinking Agent and Chain Extender on Properties of Gamma-Irradiated PLA. J. Polym. Environ. 2017, 25, 323–333. [Google Scholar] [CrossRef]
- Madera-Santana, T.J.; Meléndrez, R.; González-García, G.; Quintana-Owen, P.; Pillai, S.D. Effect of gamma irradiation on physicochemical properties of commercial poly(lactic acid) clamshell for food packaging. Radiat. Phys. Chem. 2016, 123, 6–13. [Google Scholar] [CrossRef]
- Kodama, Y.; Machado, L.D.B.; Giovedi, C.; Nakayama, K. Gamma radiation effect on structural properties of PLLA/PCL blends. Nucl. Instrum. Methods Phys. Res. Sect. B 2007, 265, 294–299. [Google Scholar] [CrossRef]
- Razavi, S.M.; Dadbin, S.; Frounchi, M. Effect of gamma ray on poly (lactic acid)/polyvinyl acetate-co-vinyl alcohol) blends as biodegradable food packaging films. Radiat. Phys. Chem. 2014, 96, 12–18. [Google Scholar] [CrossRef]
- Zaidi, L.; Bruzaud, S.; Kaci, M.; Bourmaud, A.; Gautier, N.; Grohens, Y. The effects of gamma irradiation on the morphology and properties of polylactide/Cloisite 30B nanocomposites. Polym. Degrad. Stab. 2013, 98, 348–355. [Google Scholar] [CrossRef]
- Chieng, B.W.; Ibrahim, N.A.; Wan Yunus, W.M.Z.; Hussein, M.Z. Poly(lactic acid)/Poly(ethylene glycol) Polymer Nanocomposites: Effects of Graphene Nanoplatelets. Polymers 2014, 6, 93–104. [Google Scholar] [CrossRef] [Green Version]
- Rao, B.S.; Rao, T.V.; Madhukar, K.; Mouli, C.; Kalahasti, S.; Rao, K.G.K. ESR and FTIR study of gamma irradiated poly(ethylene glycol). Int. J. Chem. Sci. 2009, 7, 2434–2440. [Google Scholar]
- Shahabi, S.; Najafi, F.; Majdabadi, A.; Hooshmand, T.; Nazarpak, M.H.; Karimi, B.; Fatemi, M.S. Effect of Gamma Irradiation on Structural and Biological Properties of a PLGA-PEG-Hydroxyapatite Composite. Sci. World J. 2014, 420616. [Google Scholar] [CrossRef] [PubMed]
- Montanari, L.; Costantini, M.; Signoretti, E.C.; Valvo, L.; Santucci, M.; Bartolomei, M.; Fattibene, P.; Onori, S.; Faucitano, A.; Conti, B.; et al. Gamma irradiation effects on poly(dl-lactictide-co-glycolide) microspheres. J. Control. Release 1998, 56, 219–229. [Google Scholar] [CrossRef]
- Bhalla, H.L.; Menon, M.R.; Gopal, N.G.S. Radiation sterilization of polyethylene glycols. Int. J. Pharm. 1983, 17, 351–355. [Google Scholar] [CrossRef]
- Negrea, P.; Caunii, A.; Sarac, I.; Butnariu, M. The study of infrared spectrum of chitin and chitosan. Extract as potential sources of biomass. Dig. J. Nanomater. Biostruct. 2015, 10, 1129–1138. [Google Scholar]
- Rezanejad, R.; Ojagh, S.M.; Heidarieh, M.; Raeisi, M.; Rafiee, G.; Alishahi, A. Characterization of Gamma-Irradiated Rosmarinus officinalis L. (Rosemary). Turk. J. Pharm. Sci. 2019, 16, 43–47. [Google Scholar] [CrossRef]
- Zembouai, I.; Kaci, M.; Bruzaud, S.; Dumazert, L.; Bourmaud, A.; Mahlous, M.; Lopez-Cuesta, J.M.; Grohens, Y. Gamma irradiation effects on morphology and properties of PHBV/PLA blends in presence of compatibilizer and Cloisite 30B. Polym. Test. 2016, 49, 29–37. [Google Scholar] [CrossRef]
- Wenwei, Z.; Xiaoguang, Z.; Li, Y.; Yuefang, Z.; Jiazhen, S. Some chemical changes in chitosan induced by gamma-ray irradiation. Polym. Degrad. Stab. 1993, 41, 83–84. [Google Scholar] [CrossRef]
- Marianti, A.; Anggraito, Y.U.; Christijanti, W. Effective gamma irradiation dose on viscosity and molecular weight reduction of chitosan. J. Phys. Conf. Ser. 2020, 1567, 042096. [Google Scholar] [CrossRef]
- Desai, K.G.; Park, H.J. Study of Gamma-Irradiation Effects on Chitosan Microparticles. Drug Deliv. 2006, 13, 39–50. [Google Scholar] [CrossRef]
- Zaharescu, T.; Râpă, M.; Lungulescu, E.M.; Butoi, N. Filler effect on the degradation of γ-processed PLA/vinyl POSS hybrid. Radiat. Phys. Chem. 2018, 153, 188–197. [Google Scholar] [CrossRef]
- Lim, L.Y.; Khor, E.; Koo, O. Gamma irradiation of chitosan. J. Biomed. Mater. Res. 1998, 43, 282–290. [Google Scholar] [CrossRef]
- Zaharescu, T.; Pleşa, I.; Jipa, S. Improvement in the degradation resistance of LDPE for radiochemical processing. Radiat. Phys. Chem. 2014, 94, 151–155. [Google Scholar] [CrossRef]
- Musuc, A.M.; Badea-Doni, M.; Jecu, L.; Rusu, A.; Popa, V.T. FTIR, XRD, and DSC analysis of the rosemary extract effect on polyethylene structure and biodegradability. J. Therm. Anal. Calorim. 2013, 114, 169–177. [Google Scholar] [CrossRef]
- Lungulescu, M.; Zaharescu, T.; Jipa, S.; Setnescu, R.; Setnescu, T. Chemiluminescence study on γ-irradiated EPDM/IIR blends. J. Optoelectron. Adv. Mater. 2008, 10, 834–836. [Google Scholar]
- Rychý, J.; Rychlá, L.; Stloukal, P.; Koutný, M.; Pekařová, S.; Verney, V.; Fiedlorová, A. UV initiated oxidation and chemiluminescence from aromatic-aliphatic copolyesters and polylactic acid. Polym. Degrad. Stab. 2013, 98, 2556–2563. [Google Scholar] [CrossRef]
- Nugroho, P.; Mitoshi, H.; Yoshii, F.; Kume, T. Degradation of poly(L-lactic acid). Polym. Degrad. Stab. 2001, 72, 337–343. [Google Scholar] [CrossRef]
- Babanalbandi, A.; Hill, D.J.T.; Whittaker, A.K. Volatile products and new polymer structures formed on 60Co γ-radiolysis of poly(lactic acid) and poly(glycolic acid). Polym. Degrad. Stab. 1997, 58, 203–214. [Google Scholar] [CrossRef]
- Lin, H.Y.; Tsai, S.Y.; Yu, H.T.; Lin, C.P. Degradation of Polylactic Acid by Irradiation. J. Polym. Environ. 2018, 26, 122–131. [Google Scholar] [CrossRef]
- González-Torres, M.; Guzmán-Beltrán, S.; Mata-Gómez, M.A.; González-Valdez, J.; Leyva-Gómez, G.; Melgarejo-Ramírez, Y.; Brostow, W.; Velasquillo, C.; Zúñiga-Ramos, J.; Rodríguez-Talavera, R. Synthesis, characterization, and in vitro evaluation of gamma radiation induced PEGylated isoniazid. Electron. J. Biotechnol. 2019, 41, 81–87. [Google Scholar] [CrossRef]
- Peng, H.; Varanasi, S.; Wang, D.K.; Blakey, I.; Rasoul, F.; Symons, A.; Hill, D.J.T.; Whittaker, A.K. Synthesis, swelling, degradation and cytocompatibility of crosslinked PLLA-PEG-PLLA networks with short PLLA blocks. Eur. Polym. J. 2016, 84, 448–464. [Google Scholar] [CrossRef]
- Jipa, S.; Zaharescu, T.; Kappel, W.; Dumitrescu, C.; Maris, M.; Mantsch, A.; Lungulescu, M. Scavenger capacity of natural phenolics in some selected labiatae herbs. Optoelectron. Adv. Mater.-Rapid Commun. 2008, 2, 669–673. [Google Scholar]
- Harborne, J.B.; Mabry, T.J.; Mabry, H. The Flavonoids: Advances in Research; Harborne, J.B., Mabry, T.J., Eds.; Springer Science Buisness, B.V. Media: London, UK, 1982; ISBN 978-1-4899-2915-0. [Google Scholar]
- Peppas, N.A.; Sahlin, J.J. A simple equation for the description of solute release. III. Coupling of diffusion and relaxation. Int. J. Pharm. 1989, 57, 169–172. [Google Scholar] [CrossRef]
- Peppas, N.A. Analysis of Fickian and non-Fickian drug release from polymers. Pharm. Acta Helv. 1985, 60, 110–111. [Google Scholar] [PubMed]
- Tehrany, E.A.; Desobry, S. Partition coefficients in food/packaging systems: A review. Food Addit. Contam. 2004, 21, 1186–1202. [Google Scholar] [CrossRef]
- Fortunati, E.; Peltzer, M.; Armentano, I.; Torre, L.; Jiménez, A.; Kenny, J.M. Effects of modified cellulose nanocrystals on the barrier and migration properties of PLA nano-biocomposites. Carbohydr. Polym. 2012, 90, 948–956. [Google Scholar] [CrossRef]
- Rashid, T.U.; Rahman, M.M.; Kabir, S.; Shamsuddin, S.M.; Khan, M.A. A new approach for the preparation of chitosan from γ-irradiation of prawn shell: Effects of radiation on the characteristics of chitosan. Polym. Int. 2012, 61, 1302–1308. [Google Scholar] [CrossRef]
- Khalil, S.A.; Hassan, M.S.; Ali, N.M. Characterization and Antimicrobial Properties of Gamma Irradiated Starch/Chitosan/Ag Nanocomposites. Arab. J. Nucl. Sci. Appl. 2016, 94, 1–11. [Google Scholar]

| Nr. | Sample | Polylactic Acid (PLA) (wt%) | Rosemary Extract (R) (wt%) | Poly(ethylene glycol) (PEG) (wt%) | Chitosan (CS) (wt%) |
|---|---|---|---|---|---|
| 1 | PLA | 100 | - | - | - |
| 2 | PLA/0.25R | 99.75 | 0.25 | - | - |
| 3 | PLA/0.5R | 99.50 | 0.5 | - | - |
| 4 | PLA/0.75R | 99.25 | 0.75 | - | - |
| 5 | PLA/PEG/3CS | 77 | - | 20 | 3 |
| 6 | PLA/PEG/3CS/0.5R | 76.5 | 0.5 | 20 | 3 |
| 7 | PLA/PEG/6CS | 74 | - | 20 | 6 |
| 8 | PLA/PEG/6CS/0.5R | 73.5 | 0.5 | 20 | 6 |
| Sample | Dose (kGy) | Tg (°C) | Tcc (°C) | Tm (°C) |
|---|---|---|---|---|
| PLA | 10 | 65.7 | 125.8 | 150.3; 156.5 |
| 20 | 65.2 | 117.1 | 148.4; 156.2 | |
| PLA/0.25R | 10 | 65.7 | 121.5 | 157.3 |
| 20 | 63.7 | 112.3 | 158.4 | |
| 30 | 62.4 | 111.6 | 148.6; 155.7 | |
| PLA/0.5R | 10 | 66.2 | 124.1 | 150.6 |
| 20 | 63.7 | 121.3 | 143.4 sh; 156.8 | |
| PLA/0.75R | 10 | 64.9 | 126.5 | 151.0 |
| 20 | 63.7 | 122.3 | 149.2; 156.3; | |
| 30 | 63.4 | 117.9 | 147.2; 155.5 | |
| PLA/PEG/3CS | 0 | 57.6 | 86.9 | 148.8 |
| 10 | - | 82.6 | 142.5 | |
| 20 | 54.2 | 83.2 | 145.1 | |
| 30 | - | 74.6 | 126.4 sh; 134.9 | |
| PLA/PEG/6CS | 0 | 57.2 | 88.1 | 149.4 |
| 10 | 55.4 | 85.3 | 136.4 sh; 145.4 | |
| 20 | 54.5 | 85.4 | 144.5 | |
| 30 | - | 77.3 | 136.4 | |
| PLA/PEG/3CS/0.5R | 0 | 59.6 | 89.2 | 149.6 |
| 10 | 57.3 | 85.3 | 143.6 | |
| 20 | - | 81.7 | 140.8; 144.5 | |
| 30 | 56.4 | 84.0 | 137.6 sh; 144.2 | |
| PLA/PEG/6CS/0.5R | 0 | 56.3 | 89.5 | 149.4 |
| 10 | 56.6 | 84.7 | 142.8 | |
| 20 | 54.4 | 83.3 | 140.5 sh; 145.3 | |
| 30 | 54.0 | 81.2 | 140.5 |
| Sample | Dose (kGy) | Tonset (°C) | T10% (°C) | T20% (°C) | TM (°C) | Tf (°C) | Δw (%) |
|---|---|---|---|---|---|---|---|
| PLA | 10 | 272.7 | 304.2 | 313.5 | 331.7 | 356.7 | 96.4 |
| 20 | 221 | 271.6 | 278.6 | 302.9 | 326.4 | 92.4 | |
| PLA/0.25R | 10 | 255.7 | 304.2 | 313.5 | 328.4 | 358.0 | 92.5 |
| 20 | 189.9 | 248.4 | 264.9 | 277.3 | 317.9 | 90.7 | |
| 30 | 221.8 | 267.0 | 278.8 | 290.1; 302.9 | 343.4 | 89.9 | |
| PLA/0.5R | 10 | 227.9 | 283.5 | 299.6 | 320.5 | 339.2 | 94.5 |
| 20 | 189.5 | 245.9 | 262.3 | 279.4 | 313.4 | 94.5 | |
| PLA/0.75R | 10 | 232.3 | 274.5 | 292.8 | 298.2 | 319.7 | 94.5 |
| 20 | 211.2 | 257.9 | 271.6 | 292.5 | 319.9 | 94.5 | |
| 30 | 234.6 | 274.2 | 289.2 | 303.1 | 337.1 | 97.1 | |
| PLA/PEG/3CS | 0 | 203 | 276.7 | 301.6 | 351.5; 401.2 | 425 | 98.6 |
| 10 | 163 | 205.2 | 270.4 | 322.5; 398.7 | 425 | 98.6 | |
| 20 | 163 | 237 | 280.06 | 317.9; 397.9 | 425 | 98.6 | |
| 30 | 140 | 213.8 | 281 | 325.0; 399.1 | 427 | 97.8 | |
| PLA/PEG/6CS | 0 | 217 | 277.2 | 300.8 | 360; 402 | 439 | 98.8 |
| 10 | 217 | 258.6 | 289.1 | 314.9; 397.5 | 439 | 97.9 | |
| 20 | 215 | 258.6 | 278.7 | 322.7; 399.7 | 439 | 97.3 | |
| 30 | 214 | 251.9 | 280.6 | 311.9; 399.7 | 437 | 97.7 | |
| PLA/PEG/3CS/0.5R | 0 | 166 | 283 | 285 | 355.3; 403.2 | 437 | 98.5 |
| 10 | 136 | 255 | 287 | 329.7; 397.7 | 438 | 98.8 | |
| 20 | 136 | 251 | 282 | 319.7; 398.6 | 438 | 98.8 | |
| 30 | 125 | 255 | 277 | 314.5; 395.3 | 430 | 98.6 | |
| PLA/PEG/6CS/0.5R | 0 | 166 | 282 | 315.2 | 359.2; 403 | 510 | 97.8 |
| 10 | 139 | 245 | 293 | 330.7; 399.7 | 486 | 96.5 | |
| 20 | 139 | 245 | 288.9 | 326; 397.9 | 492 | 96.4 | |
| 30 | 139 | 245 | 293.9 | 323.1; 398.8 | 486 | 95.4 |
| Sample | Dose (kGy) | OOT (°C) | Correlation Factor | Activation Energy (kJ/mol) | |||
|---|---|---|---|---|---|---|---|
| Heating Rate (°C/min) | |||||||
| 3.7 | 5.0 | 10.0 | 15.0 | ||||
| Former peak | |||||||
| PLA | 10 | 85 | 88 | 100 | 115 | 0.97355 | 46.72 |
| 20 | 83 | 85 | 95 | 111 | 0.95152 | 48.38 | |
| 30 | 81 | 86 | 93 | 108 | 0.95576 | 52.79 | |
| PLA/0.5R | 10 | 85 | 87 | 98 | 110 | 0.97662 | 55.79 |
| 20 | 83 | 86 | 96 | 110 | 0.98547 | 51.78 | |
| 30 | 81 | 85 | 96 | 110 | 0.97925 | 52.80 | |
| Major peak | |||||||
| PLA | 10 | 188 | 205 | 220 | 228 | 0.96331 | 59.36 |
| 20 | 180 | 194 | 208 | 221 | 0.98400 | 58.36 | |
| 30 | 173 | 189 | 201 | 215 | 0.97138 | 55.45 | |
| PLA/0.5R | 10 | 189 | 202 | 210 | 222 | 0.96548 | 76.74 |
| 20 | 185 | 197 | 206 | 220 | 0.97323 | 71.50 | |
| 30 | 179 | 190 | 201 | 215 | 0.90371 | 67.26 | |
| PLA/PEG/3CS | 10 | 207 | 215 | 230 | 240 | 0.99902 | 74.91 |
| 20 | 198 | 206 | 225 | 232 | 0.99463 | 70.92 | |
| 30 | 189 | 200 | 212 | 230 | 0.98046 | 62.77 | |
| PLA/PEG/3CS/0.5R | 10 | 205 | 215 | 225 | 232 | 0.98261 | 98.85 |
| 20 | 199 | 208 | 220 | 228 | 0.99292 | 89.21 | |
| 30 | 189 | 205 | 212 | 218 | 0.91934 | 81.39 | |
| PLA/PEG/6CS | 10 | 189 | 205 | 212 | 216 | 0.90206 | 84.13 |
| 20 | 185 | 202 | 208 | 215 | 0.90953 | 77.32 | |
| 30 | 181 | 195 | 205 | 215 | 0.96790 | 70.91 | |
| PLA/PEG/6CS/0.5R | 10 | 208 | 217 | 231 | 238 | 0.99313 | 87.63 |
| 20 | 203 | 214 | 228 | 232 | 0.97303 | 85.63 | |
| 30 | 201 | 210 | 222 | 234 | 0.99275 | 80.15 | |
| Samples | Peppas/Power Law Model | First Order Kinetic Model | Diffusion Model | KP | C (mg/kg) | |||||
|---|---|---|---|---|---|---|---|---|---|---|
| n | R2 | k × 10−3 (h−n) | R2 | k1 (h−n) | R2 | D (m2/s) | R2 | |||
| PLA/PEG/0.5R | 0.37 | 0.99 | 85.12 | 0.98 | 5.20 × 10−3 | 0.84 | 1.7 × 10−13 | 0.98 | 1.06 | 19.2 |
| PLA/PEG/3CS/0.5R | 0.23 | 0.98 | 147.78 | 0.99 | 5.17 × 10−3 | 0.81 | 2.05 × 10−13 | 0.97 | 0.95 | 14.1 |
| PLA/PEG/6CS/0.5R | 0.38 | 0.99 | 72.92 | 0.99 | 3.7 × 10−3 | 0.92 | 1.05 × 10−13 | 0.99 | 0.64 | 18.4 |
| PLA/PEG/0.5R 30 kGy | 0.26 | 0.99 | 7.46 | 0.99 | 12.52 × 10−5 | 0.87 | 1.78 × 10−18 | 0.97 | 1.08 | 6.67 |
| PLA/PEG/3CS/0.5R 30 kGy | 0.19 | 0.99 | 6.54 | 0.99 | 8.83 × 10−5 | 0.91 | 1.08 × 10−18 | 0.98 | 1.6 | 5.8 |
| PLA/PEG/6CS/0.5R 30 kGy | 0.21 | 0.99 | 6.94 | 0.99 | 11.46 × 10−5 | 0.88 | 1.23 × 10−18 | 0.98 | 1.44 | 5.84 |
| Sample | Salmonella typhymurium | Escherichia coli | Stapylococcus aureus | ||||
|---|---|---|---|---|---|---|---|
| 0 KGy | 30 KGy | 0 KGy | 30 KGy | 0 | 10 KGy | 30 KGy | |
| PLA | 32 | 100 | 53 | 100 | 43 | 100 | 100 |
| PLA/0.25R | 52 | 61 | 39 | 100 | |||
| PLA/0.5R | 52 | 100 | 71 | 100 | 87 | 31 | 100 |
| PLA/0.75R | 55 | 94 | 42 | 100 | |||
| PLA/PEG | 29 | 100 | 69 | 100 | 44 | 58 | 100 |
| PLA/PEG/3CS | 58 | 73 | 34 | 100 | |||
| PLA/PEG/6CS | 58 | 73 | 22 | 100 | |||
| PLA/PEG/0.5R | 48 | 100 | 76 | 100 | 88 | 100 | 100 |
| PLA/PEG/3CS/0.5R | 81 | 100 | 76 | 100 | 92 | 78 | |
| PLA/PEG/6CS/0.5R | 90 | 100 | 82 | 100 | 86 | 56 | 100 |
Publisher’s Note: MDPI stays neutral with regard to jurisdictional claims in published maps and institutional affiliations. |
© 2022 by the authors. Licensee MDPI, Basel, Switzerland. This article is an open access article distributed under the terms and conditions of the Creative Commons Attribution (CC BY) license (https://creativecommons.org/licenses/by/4.0/).
Share and Cite
Vasile, C.; Pamfil, D.; Zaharescu, T.; Dumitriu, R.-P.; Pricope, G.M.; Râpă, M.; Vasilievici, G. Effect of Gamma Irradiation on the PLA-Based Blends and Biocomposites Containing Rosemary Ethanolic Extract and Chitosan. Polymers 2022, 14, 1398. https://doi.org/10.3390/polym14071398
Vasile C, Pamfil D, Zaharescu T, Dumitriu R-P, Pricope GM, Râpă M, Vasilievici G. Effect of Gamma Irradiation on the PLA-Based Blends and Biocomposites Containing Rosemary Ethanolic Extract and Chitosan. Polymers. 2022; 14(7):1398. https://doi.org/10.3390/polym14071398
Chicago/Turabian StyleVasile, Cornelia, Daniela Pamfil, Traian Zaharescu, Raluca-Petronela Dumitriu, Gina Mihaela Pricope, Maria Râpă, and Gabriel Vasilievici. 2022. "Effect of Gamma Irradiation on the PLA-Based Blends and Biocomposites Containing Rosemary Ethanolic Extract and Chitosan" Polymers 14, no. 7: 1398. https://doi.org/10.3390/polym14071398
APA StyleVasile, C., Pamfil, D., Zaharescu, T., Dumitriu, R.-P., Pricope, G. M., Râpă, M., & Vasilievici, G. (2022). Effect of Gamma Irradiation on the PLA-Based Blends and Biocomposites Containing Rosemary Ethanolic Extract and Chitosan. Polymers, 14(7), 1398. https://doi.org/10.3390/polym14071398









